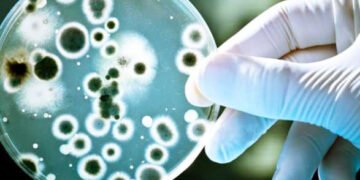
День рождения пенициллина, День позитивного мышления. Что еще можно отметить 13 сентября

КИЕВ. 13 сентября. УНН. Сегодня, 13 сентября, мир отмечает День рождения пенициллина – случайного изобретения, которое можно назвать революцией в медицине, пишет УНН.
Шотландский микробиолог Александр Флеминг исследовал различные культуры гноеродных бактерий. Он разместил их в открытых чашках Петри накануне летних каникул.
Когда вернулся, то увидел, что в некоторых чашках завелась плесень.
Считается, что именно 13 сентября 1928 года Флеминг пришел к выводу, что в одной из чашек плесень подавляет рост бактерий. Это была зеленая кистевидная плесень Penicillium notatum.
Флеминг продолжил свои эксперименты. “Враждебное” бактериям вещество, которое выделяла плесень, Флеминг назвал пенициллином.
Интересно, что ученый не попытался выделить пенициллин в чистом виде, и, вообще, не придал внимания своему открытию.
Флеминг в 1929 году лишь опубликовал статью в научном журнале. Ею заинтересовались ученые Говард Уолтер Флори и Эрнест Борис Чейн.
Они провели испытания пенициллина на животных, которые показали превосходные результаты его противодействия инфекциям.
В 1941 году в США началось массовое производство пенициллина по государственному заказу. Одним из ключевых подрядчиков была компания Pfizer, которая до того времени, вообще, не занималась медикаментами, а специализировалась на производстве лимонной кислоты.
Также сегодня можно отметить День позитивного мышления.
Это неофициальное событие было основано в 2003 году. Его цель — пропаганда идеи о том, что негативные мысли приносят больше вреда, чем пользы, они истощают, отбирают энергию. А позитивное мышление имеет прямую связь’со способностью поддерживать в себе надежду и заинтересованность несмотря на события, позитивные или негативные.
13 сентября — это еще и День дяди Сэма — вымышленного персонажа, олицетворяющего США.
Хотя у этого персонажа есть свой реальный прототип — предприниматель Сэм Уилсон, который родился 13 сентября 1776 года.
Уилсон поставлял мясо в одну из воинских частей американской армии. На бочках с ним он ставил маркировку “U.S”, имея в виду Соединенные Штаты. Но кто-то решил расшифровать эту аббревиатуру как Uncle Sam.
Визуальный образ дяди Сэма впервые появился в одной из американских газет в 1952 году. Его автором был художник-карикатурист Фрэнк Генри Белл.
Дядю Сэма он изобразил высоким, худым, пожилым мужчиной со старомодной бородой, в шляпе-цилиндре в цветах национального флага, полосатых штанах и синем пиджаке.
По церковному календарю сегодня День памяти святого Корнилия.
Корнилий жил в І веке в Кесарии, был римским воином и язычником.
По преданию, однажды мужчине явился ангел, который приказал найти апостола Петра. Корнилий послушался и выполнил приказ. Он встретился с апостолом и привел его в свой дом. После рассказа Петра об учении Христа Корнилий уверовал и решил принять крещение.
Впоследствии Петр рукоположил Корнилия в епископа. Однажды в Скепсии Корнилий зашел в языческий храм, который после его проповеди развалился. Все местные жители сразу приняли христианство.
После смерти Корнилия похоронили возле руин этого языческого храма.
Именины сегодня празднуют Александр, Владимир, Геннадий, Дмитрий, Мирон.